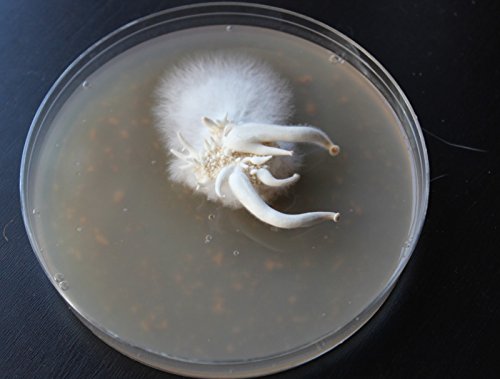
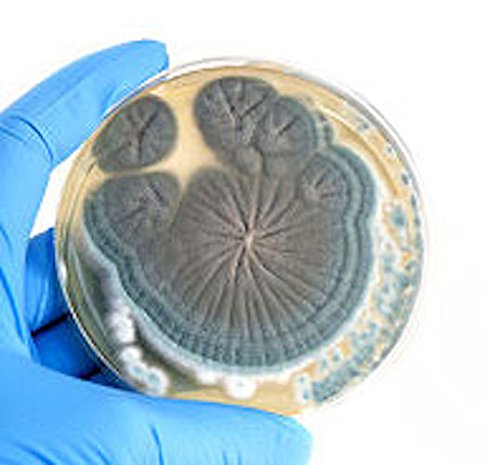

Customer Services

Summary Sabouraud Dextrose + Chloramphenicol Agar Plates are a medium designed for cultivating organism from the Kingdom of Fungi i.e. Mushroom fungi , brewing yeasts and molds. This medium has a nutritional content and low pH (pH 5.6) favourable to the growth of Fungi and inhibitory to the growth of bacteria. It also contains the broad spectrum antibiotic Chloramphenicol to inhibit bacterial growth. Technical Note Although not mandatory, it is good practice that users seal individual plates once cultures have been made e.g. using parafilm, as plates are easily contaminated. Simply opening a fridge door can introduce containments into unsealed plates, via pressure changes and draughts, potentially carrying contaminants into cavities between dish and lidDisposalFor disposal, users can soak the plates in a 5-10% household-bleach solution using warm/hot water to ensure any microbes are destroyed, before disposal in the bin. Note - once opened, the plates are no longer guaranteed sterile and prone to growth of microbes. The 3-months of guaranteed sterility is from the date of manufacture, and ends once protective packaging is opened!
Trustpilot
1 day ago
5 days ago